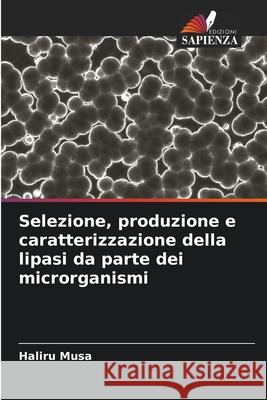
Selezione, produzione e caratterizzazione della lipasi da parte dei microrganismi Musa, Haliru 9786208855512 Edizioni Sapienza - książka

Selezione, produzione e caratterizzazione della lipasi da parte dei microrganismi » książka
topmenu
Selezione, produzione e caratterizzazione della lipasi da parte dei microrganismi
ISBN-13: 9786208855512 / Włoski / Miękka / 2025 / 100 str.
Selezione, produzione e caratterizzazione della lipasi da parte dei microrganismi
ISBN-13: 9786208855512 / Włoski / Miękka / 2025 / 100 str.
cena 250,62
(netto: 238,69 VAT: 5%)
Najniższa cena z 30 dni: 250,62
(netto: 238,69 VAT: 5%)
Najniższa cena z 30 dni: 250,62
Termin realizacji zamówienia:
ok. 10-14 dni roboczych
Bez gwarancji dostawy przed świętami
ok. 10-14 dni roboczych
Bez gwarancji dostawy przed świętami
Darmowa dostawa!
Kategorie BISAC:
Wydawca:
Edizioni Sapienza
Język:
Włoski
ISBN-13:
9786208855512
Rok wydania:
2025
Ilość stron:
100
Wymiary:
22.0 x 15.0
Oprawa:
Miękka